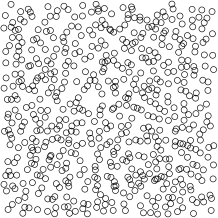
Refer to caption

The double-layer of penetrable ions: an alternative route to charge reversal
Abstract
We investigate a double-layer of penetrable ions near a charged wall. We find a new mechanism for charge reversal that occurs in the weak-coupling regime and, accordingly, the system is suitable for the mean-field analysis. The penetrability is achieved by smearing-out the ionic charge inside a sphere, so there is no need to introduce non-electrostatic forces and the system in the low coupling limit can be described by a modified version of the Poisson-Boltzmann equation. The predictions of the theory are compared with the Monte Carlo simulations.
pacs:
I Introduction
Overcharging is a surprising phenomenon in which conterions adsorbed to a surface exceed the number of fixed surface charges Pa80 . As a consequence, coions are drawn from the bulk toward the overcharged surface leading to a formation of a ”triple-layer”. Because the underlying mechanism of overcharging relies on electrostatic correlations Reviews , it has become synonymous with the strong-coupling limit. Indeed, a mean-field treatment which accurately captures the weak-coupling limit, cannot describe overcharging. (However, the mean-field in combination with the excluded volume interactions can induce overcharging if the bulk volume fraction of an electrolyte is sufficiently large to generate a depletion force that pushes particles against a surface. This effect is seen in uncharged systems and persists for weakly charged surface charges Kjellander98 ; Lozada02 ; Lozada10 ; Frydel12 .)
In the strong-coupling limit overcharging is the result of increased structuring within the layer of counterions. The electrostatic correlations between the condensed counterions lead to formation of correlation ”holes” within the layer of condensed ions which can attract excess of counterions from the bulk. The value of the coupling constant , which is the ratio between the Bjerrum and Gouy-Chapman length ( is the valency), estimates the extent of correlation effects. In the limit , the counterions are said to freeze into a 2d Wigner crystal Shklovskii99 . At large, but finite , the local structure of an ionic fluid remains Wigner-like Ro96 ; Shklovskii99 ; Sal05 ; Trizac11 . The above mechanism is specific to Coulomb interactions that diverge as and, therefore, exhibit the excluded volume effects Huang93 ; Sal05 . If, however, the divergence in the pair interaction is removed (the pair potential is bounded as ), particles can interpenetrate and the usual excluded volume interactions underlying the crystal formation are eliminated (at sufficiently high temperature and/or density). For some family of bounded potentials, particles can form stacks where two or more particles occupy the same position and act as an effective single particle. This is possible only if a pair potential is sufficiently flat around Lowen01 . One example is the penetrable sphere model where the pair potential is the step function Witten89 ; Lowen98 ; Schmidt99 ; Rosenfeld00 . The stacking formations stabilize the liquid phase Lowen98 , since doublets, triplets, etc. effectively decrease the number of particles. The presence of stacked formations is signaled as a positive peak in the pair correlation function at Lowen98 . Extrapolating these ideas to ions, which in addition to penetrable cores have long-range Coulomb interactions, we ask what influence penetrability has on the structure of a double-layer. Can the restructuring invoked by the penetrability lead to overcharging in the weak-coupling limit?
In the present work, the divergence in the Coulomb potential is removed by smearing-out the central charge of an ion over a finite region. The penetrating core, then, depends on the weight function used to smear out the charge. This procedure does not require going beyond the framework of electrostatics and the weak-coupling limit can be described by the modified version of the Poisson-Boltzmann equation.
Bulk properties and phase diagram of penetrable ions have been investigated in Hansen11a ; Hansen11b ; Hansen12 . The main feature is the formation of the Bjerrum pairs of two opposite ions that function as polarizable particles. The formation of these pairs leads to an insulator-conductor transition Hansen11a , which does not exist in systems of hard-core ions in three dimensions Yan93 . Thus, penetrability dramatically affects the phase transition and the topology of the phase diagram.
The model of penetrable particles is not only of theoretical interest. Various macroparticles can exhibit interpenetration. Marquest and Witten Witten89 suggested a penetrable sphere model for micelles. Polymer coils and dendrimers in good solvent can be represented by a Gaussian core model Hansen00 ; Schmidt01 . If in addition these macroparticles are charged, as is often the case for real systems Barrat95 , then the model of penetrable ions can be of genuine physical relevance. Recently, ionic microgels have been modeled as uniformly charged spheres Lowen04 , allowing interpenetration at short- and Coulomb interactions at long-separations.
II The Poisson-Boltzmann equation for smeared-out charges
The charge of an ion is smeared out over the finite region according to the weight function such that . The charge density operator for smeared-out ions is
| (1) |
In this work we consider a symmetric electrolyte, . The averaged charge density for this system is
| (2) |
where and denotes the number density of anions and cations, respectively. The Poisson equation is
| (3) |
where is the background dielectric constant. To obtain a closed equation, we need an expression for and in terms of the mean electrostatic potential . For point charges this leads to
| (4) |
where the subscript is either or , and is the bulk salt concentration. The number density depends locally on an electrostatic potential. However, if charge is smeared around the ion center at , the entire distribution interacts with the mean electrostatic potential,
| (5) |
and the number density becomes
| (6) |
We may now write down the mean-field equation for the electrostatic potential produced by smeared-out ions,
We refer to this modified Poisson-Boltzmann equation the Finite-Spread PB equation (FSPB). The FSPB equation complements the already quite sizable set of modified PB equations: the PB that incorporates the excluded volume interactions david97 , the dipolar interactions david07 , the nonlinear solvent contributions Frydel11a , and the polarizability of ions Frydel11 ; Roji12 . The idea of finitely spread-out ions was considered in Wang10 to study the self energy contributions beyond the mean-field. Mathematically, the FSPB equation has the structure of a convoluted equation. Each ion is convoluted according to the weight function which determines the composition of a single ion.
The Eq. (LABEL:eq:FSPB) can also be obtained by minimizing the grand potential,
| (8) | |||||
where is the thermal de Broglie wavelength and is the chemical potential. The three contributions are the electrostatic energy, entropy, and we allow the number density to fluctuate through the contact with a reservoir. The minimization recovers Eq. (6) and the application of the Poisson equation yields the FSPB model.
III Various Distributions
The concept of charge smearing is not novel to this work, but it has been evoked many times in the past both as a physical representation and a mathematical construct. The best known example (and to our knowledge the earliest) of mathematical construct is the calculation of Ewald summation to treat periodic charges Ewald21 , today the most practiced method to account for contributions due to periodic boundary conditions of a simulated system Frenkel02 , where by spreading the charge one achieves separation of interactions into the short- and long-range counterpart. Another instance of mathematical convenience is the Onsager smearing optimization to obtain the variational free energy of the strongly correlated one component plasma Rosenfeld87 . The idea of charges which at short separations exhibit soft repulsion and at long separations the Coulomb interaction appeared in Hansen81 to represent semi-classical hydrogen plasma at high temperature and density, yet no smearing procedure was used to construct this potential. The actual smearing procedure to represent physical particles was used to model electrons set in cyclotron motion by a uniform magnetic field Shklovskii96 ; Shklovskii96b . In soft matter, the smearing out procedure was used to represent microgels in Denton03 , and recently to represent charged polymers Hansen11a ; Hansen11b ; Hansen12 .
We consider a few simple, spherically symmetric distributions and the interactions that result from these distributions. A spherically symmetric charge distribution generates the following electrostatic potential,
| (9) |
To derive the above formula we applied the Gauss law to the Poisson equation, and afterwards we integrated the resulting electrostatic field (the integration by parts was evoked). If the distribution is uniform inside a spherical cavity,
| (10) |
where is the Heaviside function and , then the potential inside a sphere is
| (11) |
Outside the sphere the Coulomb potential is recovered. The interaction between two ions with this charge distribution is Denton03 ; Rosenfeld87
| (12) |
For non-overlapping separations, ions behave like point charges. Next, we consider the distribution
| (13) |
where a charge is smeared-out over a spherical shell. Inside a sphere, the electrostatic potential is constant,
| (14) |
The interaction between two of these distributions for overlapping separations is
| (15) |
A sphere and a shell distributions interact via
| (16) |
Finally, we consider a Gaussian distribution Ewald21 ; Hansen11a ; Hansen11b ; Hansen12 ,
| (17) |
which leads to the following pair interaction
| (18) |
IV Numerical results for the FSPB equation
We primarily focus on the distribution
| (19) |
where is the ionic volume. The FSPB equation in reduced units reads
where
| (20) |
, is the screening length, and is the Bjerrum length. The number density of each species is
| (21) |
All the ions occupy the half-space . The charged hard wall at determines boundary conditions,
| (22) |
where is the surface charge. Note that the number density is limited to the region , but the charge density, because of the distribution , reaches all the way to , the location of the charged wall. Consequently, we assume the (hard-sphere)-(hard-wall) potential between an ion and the wall. Subsequent figures show data points for , the region available to ion centers.
In the dilute limit (), overcharging does not happen, the solution of the PB equation for point ions in the weak-coupling limit yields an algebraic density profile,
| (23) |
In the strong-coupling limit the electrostatic correlations modify the functional form of the distribution Netz00 ,
| (24) |
where is the Gouy-Chapman length. The barometric-like distribution in the transverse direction is a consequence of high degree of ordering in the lateral direction reminiscent of the Wigner crystal Shklovskii99 ; Trizac11 .
Although the FSPB equation is purely mean-field, we find similar modification of the density profile, but this time the relevant parameter is . The limit corresponds to the ionic distribution given by Eq. (23), and the limit to the one given by Eq. (24), see Fig. (1). In the limit , see Eq. (12), we recover an ideal gas particles in a uniform gravitational field.
Fig. (2) shows the counterion profiles for an electrolyte solution. This introduces a length scale . Counterions from the bulk can now overcharge the surface. The counterion profile beyond dips below the bulk value, which indicates an overcharged surface. Fig. (3) shows how the coion density rises above the bulk value, another signature of charge reversal. Finally, Fig. (4) shows the non-monotonic electrostatic potential which goes to negative values and has a minimum around , at which point the electrostatic field vanishes and, farther on, it changes sign.
Under what conditions penetrability of ions leads to charge reversal? For penetration to take place, either the thermal fluctuations must exceed the interaction energy of the overlapped particles, , or the counterion concentration at the wall must be sufficiently large to involve numerous overlaps, such that the effective 2D density within the counterion layer is . For the distribution in Eq. (19) the first requirement translate into , and, assuming , the second one becomes . In Fig. (2) and , and so both criteria are met.
As a parenthetical note, we point out that the PB and the FSPB models satisfy the same contact value relation,
| (25) |
where is the ideal gas pressure in the bulk, and is the total density in the bulk and at the contact with a wall, respectively.
IV.1 Tuning of the short-range interactions
The sole constraint that needs to satisfy is that its integral recovers the charge of an ion. This leaves sufficient room to manipulate the short-range interactions. As an example we can take a mixed distribution
comprised of a charged shell and sphere. is the surface area of a sphere. is the additional parameter and corresponds to the distribution in Eq. (19). The number density is
| (27) |
where
| (28) |
Fig. (5) plots the pair potentials for different . The parameter controls the strength of the repulsion and, by the same token, the strength of the excluded volume interactions.
By way of example, Fig. (6) shows the density profile for and , for . The excluded volume contributions for expel counterions from the first layer, which is the opposite of overcharging seen for .
With this example we try to demonstrate possible extensions of the model based on charge spreading. For example, the repulsion controlled by the parameter could represent the interaction between polymers on account of the self-avoiding walk of polymer chains.
V Comparison with Simulation
To test the mean-field approximation implicit in the FSPB equation, we carry out Monte Carlo simulations. The size of the simulation box is and . The periodic boundary conditions are in the lateral -directions. The bounding plates at and have opposite charge. The box encloses ions, . To check for the finite size effects, we double the simulation size for some parameters. The standard Ewald summation is applied for contributions of periodic images Frenkel02 . If particles overlap, we supplement the interaction energy with the term: . (A physical picture is slightly modified when doing simulations. In simulations we tend to think of particles as point charges which at separations switch to the non-Coulomb interactions . Within the mean-field theory based on the Poisson equation, we tend to think of an ion as a charged ball. The two conceptions are, however, identical. )
Fig. (7) compares counterion profiles obtained from the simulation and the FSPB equation. For the agreement is virtually exact. For the smaller radius we see the two results deviate: in the simulation, the correlations generate a more concentrated layer of counterions (but no overcharging). In Fig. (8) we plot the coion density profile for to further confirm the accuracy of the mean-field in this regime.
What causes charge reversal for smeared-out ions? Do counterions merely penetrate or the pair potential is sufficiently flat in the overlap region and counterions collapse into stacked formations, so that the pair correlation function exhibits positive peak as ? In Fig. (9) we show the configuration snapshots for counterions adsorbed on a charged surface for different values of . The difference in structure is perceptible. Ionic penetration favors smaller separations between counterions. This gives the impression of string-like formations.
![]() |
|
As mentioned in the introduction, not all penetrable potentials can lead to stacked configurations, where two or more particles occupy ”the same” space. For example, the Gaussian core model precludes Stillinger ; Lowen00 , while the penetrable sphere model favors the stacked configurations Lowen98 ; Schmidt99 . Stable stacked aggregates require that a pair potential be sufficiently flat. A more rigorous test involves the Fourier transform of the pair interaction. If oscillates, and, therefore, involves negative values, then the stacking takes place under certain conditions Lowen01 . On the other hand, if is non-negative, stacking does not occur under any conditions. This criterion is arrived at by considering the Ornstein-Zernike relation which, in the Fourier space, is
| (29) |
where and is the direct and pair correlation function, respectively. In the mean-field approximation [the exact definition is , and in the mean-field is the first term in Eq. (8)], so that
| (30) |
If we take to be the signature of stacking, and
| (31) |
then it becomes immediately clear that a non-negative always yields , and no stacking occurs. Only an oscillating can yield . In the present model particles are smeared-out charges,
| (32) |
and in the Fourier space
| (33) |
This yields
| (34) |
We see that regardless of the distribution . We conclude that soft interactions generated by charge spreading cannot lead to stacked configurations.
In Fig. (10) we show the lateral correlation function for the adsorbed coutnerions, . Penetration reduces the degree of electrostatic correlations between the ions, however, always remains negative and decreases monotonically all the way to . The small difference between the shell and the sphere distributions indicates that the exact shape of the pair potential is unimportant.
In Fig. (11) we show the probability distribution of the nearest neighbor separation for various functions. Differences are rather small and only quantitative. The Gaussian shows preference for smaller interionic separation.
Finally, we explore the validity of the mean-field for multivalent symmetric ions, . We suppose that the mean-field should deteriorate quickly for since the coupling constant . Fig. (12) shows the counterion density profiles for . For the mean-field is virtually exact and for there are small deviations. This surprising agreement can be explained with the following. Increasing naturally reduces the number of counterions required to neutralize the wall. On the other hand, a larger generates stronger overcharging so the density drop is partially compensated. The number of overlapping configurations is still large and the mean-field retains its validity. To confirm this conjecture, we check the 2D density of the counterions adsorbed on the charged wall. For , we find . The overlapping configurations are, therefore, still significant.
VI Discussion
For overcharging to occur, there must exist a mechanism that either reduces the free energy of counterions condensed on a charged surface (it becomes favorable for a counterion to leave its bulk environment) or increase the free energy of a bulk (it becomes less favorable for ions to stay in the bulk). It is the exchange between the two environments, the bulk and the double-layer, that leads to overcharging. We consider the environment of a charged surface with its adsorbed counterions and consider the conditions that lead to lowering of its energy. The surface charge of a plate is . We do not violate the condition of neutrality, thus the 2D density of adsorbed counterions is . We focus on the energy of a single counterion. For sake of simplicity, we assume counterions and the charged wall occupy the same plane. An attraction to the wall yields a negative energy contribution,
| (35) | |||||
which is countered by the repulsive interactions with other counterions,
| (36) |
where is the pair distribution function. For absence of correlations , and the attractive contribution is completely canceled out,
| (37) |
But the cancellation will not be exact if correlations are present. Separating correlations from the pair distribution function, , the uncanceled correlation energy is
| (38) |
The relation between the correlation energy and the correlation function is quite clear. An ion will generate a negative correlation hole in its neighborhood, which will lead to negative energy contributions. We assume the following simple correlation hole, and , that is, by fixing a position of an ion, we introduce a circular hole in the density profile with the correlation length . The conservation of mass condition requires that an area of the hole is related to the density via , therefore, the correlation length is . This correlation function is the low temperature limit of the correlation hole obtained by construction from the linear mean-field treatment Nordholm84 . Inserting this into Eq. (38) we can approximate the correlation energy in the strong-coupling limit,
| (39) |
Recalling the definition of the coupling constant , we get
| (40) |
But for penetrable ions correlations are not required for reducing the electrostatic energy of counterions – the fact demonstrated by the validity of the mean-field theory. Consequently, we set . The reduction in electrostatic energy comes from a different source, from the fact that at overlapping separations, , the electrostatic interactions are reduced on account of smearing procedure, which leads to the energy gain
| (41) | |||||
where the constant depends on the pair potential , which, in turn, is determined by the distribution function . For the distributions considered in this work: , , and . Comparing Eq. (39) with Eq. (41) we see the different dependence of each mechanism on different parameters. The stabilization based on penetration has stronger dependence on the surface charge and the Bjerrum constant, on the other hand, its dependence on valency is weaker. In the strong-coupling limit, penetrable ions will exhibit correlated motions. If the correlation length is larger than the diameter of an ion, , penetration may be neglected and the former mechanism comes to the fore. On the other hand, if , we expect the two contributions to mix.
To recap, both mechanisms depend on eliminating the energy contributions coming from short separations between ions. For point ions in the strong-coupling limit, configurations with short separations are eliminated through correlated motion. The price is sacrifice in entropy, despite this, the total free energy is lowered. For penetrable ions the problem of high energy contributions at short separations does not exist to begin with. Due to smearing out procedure of an ion charge and the removal of the divergence from pair interactions, these contributions are taken out of the picture. Consequently, there is no entropy price to be paid, as all separations are explored ”equally” and the mechanism is valid in the weak-coupling limit.
VII Conclusion
The present work studies the structure of a double-layer composed of ions whose central charge is smeared over a finite region in accordance with a weight function . The smearing-out procedure removes the divergence as from the pair interaction, allowing for interpenetration between the ions. The conditions under which penetration is favored are large temperature and high density. This regime is suitable for the mean-field treatment. Accordingly, we derive a modified Poisson-Boltzmann equation for spread-out charges (the FSPB equation). The FSPB equation predicts that for sufficiently large spreading radius , overcharging takes place – the MC simulations verify this prediction. This suggests an alternative mechanism for charge reversal that is not related to correlations and the strong-coupling limit.
Using simulations and the mean-field approximation, we can exclude the ionic stacking as the underlying mechanism of overcharging. In fact, any soft repulsion obtained by charge spreading cannot lead to stacked configurations.
As a final consideration, we address the physical relevance of the smeared-out ion model. The spreading-out of the charge may capture the interactions between charges distributed along the polymer chains, but a more realistic representation would involve a non-electrostatic component produced by the self-avoidance of the polymer chains. Within the electrostatics framework, we have suggested a plausible distribution composed of a charged shell and sphere, which generates an additional repulsion inside a penetrable core. In the end, however, a physically accurate pair potential requires corroboration with experimental analysis.
Acknowledgements.
D.F. is grateful to Nathan Berkovits for an invitation to and short sojourn in the ICTP-SAIFR where, prompted by the theoretical atmosphere of the institute, the formal aspects of the FSPB equation were laid down. This work was partially supported by the CNPq, FAPERGS, INCT-FCx, and by the US-AFOSR under the grant FA9550-12-1-0438.References
- (1) G. M. Torrie and J. P. Valleau, J. Chem. Phys. 73, 5807 (1980); E. Gonzales-Tovar, M. Lozada-Cassou and D. Henderson, J. Chem. Phys. 83, 361 (1985); M. Lozada-Cassou, R. Saavedra-Barrera and D. Henderson, J. Chem. Phys. 77, 5150 (1982).
- (2) A. Yu. Grosberg, T. T. Nguyen, and B. I. Shklovskii, Rev. Mod. Phys. 74 329 (2002); Y. Levin, Rep. Prog. Phys. 65, 1577 (2002); W.M. Gelbart, R. F. Bruinsma, P. A. Pincus, and V. A. Parsegian, Phys. Today 53, 38 (2000); F. J. Solis and M. O. de la Cruz, ibid. 54, 71 (2001).
- (3) H. Greberg and R. Kjellander, J. Chem. Phys. 108, 2940 (1998).
- (4) R. Messina, E. González-Tovar, M. Lozada-Cassou, and C. Holm, Europhys. Lett. 60, 383 (2002).
- (5) G. Iván Guerrero-Garcia, E. Gonzáles-Tovar, M. Chávez-Páez, M. Lozada-Cassou, J. Chem. Phys. 132, 054903 (2010).
- (6) D. Frydel and Y. Levin, J. Chem. Phys. 137, 164703 (2012).
- (7) I. Rouzina, V. Bloomfield, J. Chem. Phys. 100 9977 (1996).
- (8) V. I. Perel and B. I. Shklovskii, Physica A 274, 446 (1999); B. I. Shklovskii, Phys. Rev. E 60, 5802 (1999); B. I. Shklovskii, Phys. Rev. Lett. 82, 3268 (1999);
- (9) S. Pianegonda, M. C. Barbosa, and Y. Levin, Europhys. Lett. 71, 831 (2005); A. Diehl and Y. Levin, J. Chem. Phys. 129, 124506 (2008); A. P. dos Santos, A. Diehl, and Y. Levin, J. Chem. Phys. 132, 104105 (2010).
- (10) L. Šamaj and E. Trizac, Phys. Rev. Lett. 106, 078301 (2011).
- (11) G. A. McConnell, A. P. Gast, J. S. Huang, and S. D. Smith, Phys. Rev. Lett. 71, 2102 (1993).
- (12) C. N. Likos, A. Lang, M. Watzlawek, and H. Löwen, Phys. Rev. E 63, 31206 (2001).
- (13) C. Marquest and T. A. Witten, J.Phys. (France) 50, 1267 (1989).
- (14) C. N. Likos, M. Watzlawek, and H. Löwen, Phys. Rev. E 58, 3135 (1998).
- (15) M. Schmidt, J. Phys.: Condens. Matter 11, 10163 (1999).
- (16) Y. Rosenfeld, M. Schmidt, M. Watzlawek, H. Löwen, Phys. Rev. E 62, 5006 (2000).
- (17) D. Coslovich, J.P. Hansen and G. Kahl, Soft Matter 7, 1690 (2011).
- (18) D. Coslovich, J.P. Hansen and G. Kahl, J. Chem. Phys. 134, 244514 (2011).
- (19) A. Nikoubashman, J.P. Hansen and G. Kahl, J. Chem. Phys. 137, 94905 (2012).
- (20) M. E. Fisher and Y. Levin, Phys. Rev. Lett. 71, 3826 (1993).
- (21) C. N. Likos, M. Schmidt, H. Löwen, M. Ballauff, D. Pötschke, P. Lindner, Macromolecules 34, 2914 (2001).
- (22) A. A. Louis, P. G. Bolhuis, J. P. Hansen, and E. J. Meijer, Phys. Rev. Lett. 85, 2522 (2000).
- (23) J.-L. Barrat and F. Joanny, Adv. Chem. Phys. 94, 1 (1996).
- (24) D. Gottwald, C. N. Likos, G. Kahl, and H. Löwen, Phys. Rev. Lett. 92 68301 (2004).
- (25) I. Borhukov, D. Andelman, and H. Orland, Phys. Rev. Lett. 79, 435 (1997).
- (26) A. Abrashkin, D. Andelman, and H. Orland, Phys. Rev. Lett. 99, 077801 (2007).
- (27) D. Frydel and M. Oettel, Phys. Chem. Chem. Phys. 13, 4109 (2011).
- (28) D. Frydel, J.Phys. Chem. 134, 234704 (2011).
- (29) M. M. Hatlo, R. van Roij and L. Lue, Europhys. Lett. 97, 28010 (2012).
- (30) Z.-G. Wang, Phys. Rev. E 81, 21501 (2010).
- (31) P. Ewald, Ann. Phys. 369, 253 (1921).
- (32) D. Frenkel and B. Smit, Understanding Molecular simulation: from Algorithms to Applications, Academic Press, 2nd edition, (2002); M. P. ALLEN and. D. J. Tildesley, Computer Simulation of Liquids, Oxford University Press, (1989).
- (33) Y. Rosenfeld, Phys. Rev. A 35, 938 (1987); J. Stein, D. Shalitin, Y. Rosenfeld, Phys. Rev. A 37, 4854 (1988).
- (34) J.-P. Hansen and I. R. McDonald, Phys. Rev. A 83, 2041 (1981).
- (35) A. A. Koulakov, M. M. Fogler, and B. I. Shklovskii, Phys. Rev. Lett. 76, 499 (1996);
- (36) M. M. Fogler, A. A. Koulakov, and B. I. Shklovskii, Phys. Rev. B 54, 1853 (1996).
- (37) A. R. Denton, Phys. Rev. E 67, 11804 (2003).
- (38) A. G. Moreira and R. R. Netz, Europhys. Lett 52, 705 (2000).
- (39) F. H. Stillinger, J. Chem. Phys. 65, 3968 (1976). F. H. Stillinger and T. A. Weber, J. Chem. Phys. 68, 3837 (1978). F. H. Stillinger and D. K. Stillinger, Physica A 244, 358 (1997).
- (40) A. Lang, C. N. Likos, M. Watzlawek, and H. Löwen, J. Phys.: Condens. Matter 24, 5087 (2000).
- (41) S. Nordholm, Chem. Phys. Lett. 105, 302 (1984).